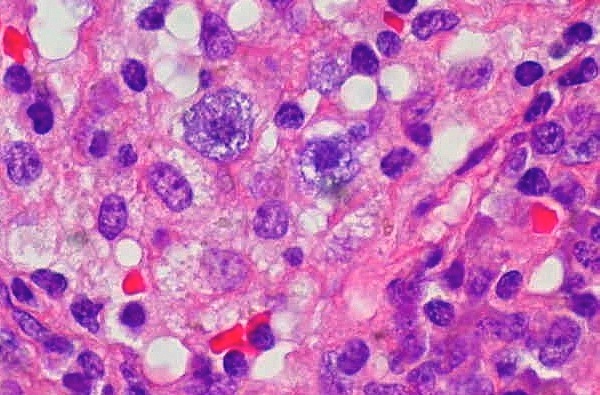

The Challenge: Incorporate an open source community service project into every class.
What happens to a student paper or project after the individual turns it in or presents it in class? Where does it go? What, ultimately, is at stake for the student when s/he sits down to apply his or her thoughts to paper? What mediums do these thoughts and ideas travel through and whom they reach? What impact does their effort make beyond the classroom?
These are questions of vital importance to every educator and pedagogue practicing today. Yet, in many cases, the answers to these questions are not particularly noteworthy. Students’ efforts in the classroom ultimately solidify into one definitive mark or grade, which too often denotes the end of the assignment’s life. There is, of course, a small percentage of student projects and papers that make their way into a conference or journal; but more often than not, they will end up archived on a hard-drive, somewhere, for a little while, and then deleted.
I try to discover ways in which students’ work will continue to thrive far beyond the limitations of a traditional classroom assignment. For instance, what would happen if a student project could be combined with the efforts and labor hours of thousands of other students, compiled online, and made accessible to the networked world? The idea is not as radical as it might sound. In fact, it’s a guiding principle behind the myriad Open Source (OS) communities online. These communities rely on the knowledge and effort of massive crowds to complete important tasks. Thus, individual knowledge becomes a vital part of the information landscape that makes up the Internet.
A project organized to include OS contribution serves a lifetime of educating others online. Duolingo, for example, mirrors classroom translation assignments but with one crucial difference: once translated, the passage becomes part of a website previously unavailable to individuals who read that particular language. The process of translating Spanish or French or German, then, provides monolinguistic speakers further access to information on the Internet. This point, I believe, is a key component in encouraging lifelong scholarship and in developing individuals who engage with the world, learn from it, and most importantly contribute to it. Designing assignments that enable students to engage with the already critical and active OS communities gives the project value extending far beyond the reach of one specific classroom.
OS contribution would have more reach, even, than publishing in a traditional academic journal, where the work would only be accessible to individuals with research library privileges. Such a shift, then, emphasizes not only collaborative communities over individual scholarship, but also OS contribution over single-author publication. Individual scholars are, as they always have been, voices in a conversation, but the process becomes more fluid, more dynamic.
I challenge myself to plan at least one Open Source community project per class. The technological infrastructure is already there, so implementing an OS assignment doesn’t require any programming or database management. Instead, I focus on the framework. To do so, I grapple with the question, how do I prepare my students to participate in diverse digital spaces in such a way that their participation both benefits the needs of the OS project and generates critical engagement with and reflection on my course themes?
The answer to this question will vary from class to class, depending on the subject area and class goals, amongst other concerns. One specific example, however, is when I assign students in a digital composition class to engage with Wikipedia, I begin the unit with multiple readings and discussions contextualizing the community they are about to enter. I introduce my class to the scholarship of Juha Suoranta and Tere Vaden (described in more detail below) to highlight exactly how Wikipedia serves as a learning device and dialogic knowledge community, rather than the faulty encyclopedia they know first as the site their high schools blocked. I explain, with examples taken directly from the Wikipedia “History” and “Talk” pages, that each article has a complex and ongoing rhetorical argument written into the language. I find it exceedingly important to provide my students with the framework that allows them to participate in the community successfully and to identify these digital spaces as dynamic and expansive fields of cultural exchange and discursive thought. In fact, just last week, I received the following Tweet, that hints at that very concept (which I promptly favorited so I can analyze and use it as a timely example with my next group of students):
There’s an interesting story to be told about ed-tech, based on the who and what of Wikipedia edits. See: “MOOCs” en.wikipedia.org/w/index.php?ti…
— Audrey Watters (@audreywatters) April 17, 2013
Some of the fundamental components of a contemporary, hybrid education, are summarized in the works of Juha Suoranta and Tere Vaden, two Finnish scholars and pedagogues who conceptualize the notion of “wikilearning.” This movement includes many elements commonly associated with a flipped classroom, such as peer-to-peer interaction, problem-based learning, and local, contextual ad hoc-learning (or knowledge emerging from discussion). Moreover, Suoranta and Vaden describe the “radical openness” and “voluntary participation” inherent in this new form of education. This shift creates a particular type of knowledge community. One that favors folksonomies (a user-driven approach to knowledge creation and organizing information) over taxonomies, and reflective uncertainty over unreflective certainty. Ultimately, the authors conclude, “everybody has equal possibility for contributing, commenting, and working on the materials from from the start,” and that is an empowering education.
Effective integration is key. I am well aware that the Internet has enough defunct student sites and classroom blogs to last a lifetime. To prevent this tragedy from occurring with the type of projects I suggest in this post, I argue for two essential elements.
- First, instructors must be critical in designing how their students interact within online spaces and how they present information online. Online communities are authentic communities. If you unleash a class of unaware or ill-equipped students onto an unexpecting Wiki article, the community responds negatively.
- Instructors must be willing to collaborate. Sure, the independence of a class-specific digital space is nice, but the derelict frame it leaves behind after the semester ends proves just as unproductive and counter-intuitive as the class project I mentioned at the beginning of this post. Twenty or thirty students cannot accomplish much online, and especially not over the course of just one semester; the field is simply too large. Focus on framing the experience, then, and leave the infrastructure to the expert programmers involved in the OS community.
There are any number of solutions to this problem. Here, I will present a couple just to get the ideas rolling. I find solace in knowing that the Internet has a thriving OS ecosystem that is full of ongoing projects to choose from. Anyone can participate. Moreover, these OS community projects provide the students an opportunity to use a more collaborative learning method, allowing them to contribute, comment, and work on the material and receive real-time feedback and support.
On a more methodological note, OS projects vary in content and goals as widely as the academic curriculum itself, strengthening the opportunity to collaborate across disciplines. For example, students in Computer Science can download OS software, play with and develop add-ons and plugins for pre-existing programs they find important (sourceforge.net, for example); or history students can transcribe and digitize manuscripts (Transcribe Bentham or DIY History, for starters), or curate and annotate historical maps (Hypercities, to name just one). Opportunities like these exist in every discourse.
The Practice: Design assignments that require students to participate and create in ongoing collaborative projects, and to critically reflect on these experiences.
As a composition instructor, I find it infinitely more valuable for a student to spend ten to twenty hours editing a series of Wikipedia articles over the course of the semester than handing in two or three drafts of the same paper. This must be done, however, with proper framework, a thorough understanding of how the Wiki community functions, and a comprehensive understanding of the history, discussion, and content of the article. If you worry about assessing such an assignment, try pairing these OS projects with either an essay reflecting on the experience or an argumentative paper that provides the critical justifications of the changes they edited into the article. Both projects are formative, both recursive and process-oriented. The difference, however, is that the former dies the moment I dole out a grade. The latter serves as a lasting and dynamic tome of knowledge for the global community. Even if, as the skeptics might have it, every last byte of data the individual shares with the community is ultimately revised out of the article, it continues to play a vital role in the evolution of the project, in the same way as the telegraph paved the way for the telephone.
Nothing is lost.
I encourage readers to share a variety of OS projects that you might have come across in your Internet browsing and research, either in the comment field below or more widely across your personal and professional networks. You will not have to look far to see how many projects are out there, relying on community participation.
[Photo by euthman]